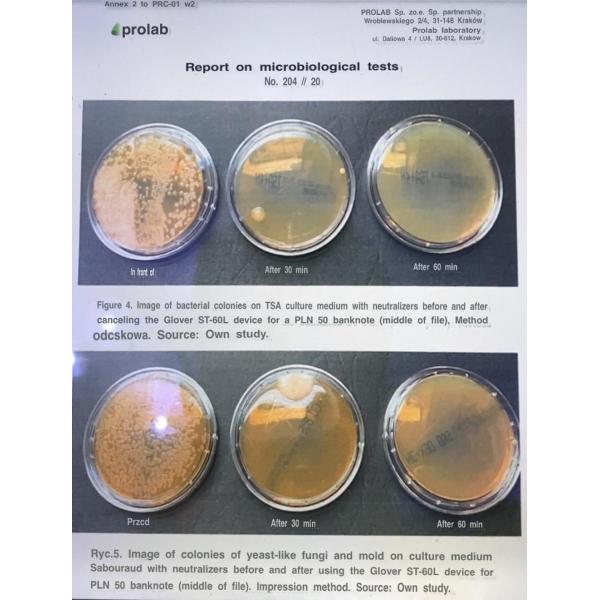

| Sign In | Join Free | My wpc-board.com |
|
Brand Name : FOLKTRONICS
Model Number : FT-80L
Certification : CE etc
Place of Origin : CHINA
MOQ : 1PC
Price : talk
Payment Terms : T/T
Supply Ability : 20000PCS/MONTH
Delivery Time : 5-10DAYS
Packaging Details : Carton box
Why temperature 65 degree can kill COVID-19 virus?
A rapid advice guideline for the diagnosis and treatment of 2019 novel coranavirus(2019-nCoV) infected pneumonia(standard verson) and US National lIBARARY of Medicine National Institutes of Health mentioned that Overall a thermal disinfection at 60°C for 30 min, 65°C for 15 min and 80°C for 1 min was effective to strongly reduce coronavirus infectivity by at least 4 log10.
Reference:https://www.ncbi.nlm.nih.gov/pmc/articles/PMC7271332/
FOLKTRONICS Banknote Sterilization Machine Unique Heat System:
*Long lifespan
*Real heat circle air
*Can reach real 65 degree and will not burn money and documents
*Only FOLKTRONICS sterilization machine can reach 65 degree heat air


Others:
*Infrared heat tube
*Lifespan: 3000hours
*If produce 65 degree heat will burn money and documents

Folktronics banknote sterilization machine pass Poland Lab Test and Pakistan Government ministry Lab Test

FOLKTRONICS UV tube pass CE, ROHS, FC certificates and Gmicro Testing



Features:
★Ultraviolet, Ozone, Heat Air
★High Quality Stainless Steel Body
★Efficient in Power Saving
★Safety and Easy Operation
★Fully Kill Virus
Production Description:
The banknote sterilization machine is assembled with UV, Ozone, heating system, over heat protection system, which is reliable for the sterilizing effect, convenient of operation and energy conservation. The sterilizer has no harm to the banknotes and is safe and convenient in use. It can effectively kill various pathogenic microorganisms tainted on the banknotes such as SARS virus, COVD19 flu virus and tubercle bacillus, with high sterilizing rate reaching the national and international disinfection and sterilization standards. The banknote sterilization machine is widely applied to the disinfection of banknotes, bill, book, tick, documents, letter received by banks, Post office, airport, bus station, store, custom, hotels etc. It is ideal equipment for areas of infectious diseases and epidemic victims.
Characteristics:
*Fully automatically, no need for supervision, easy to use
*The disinfection process will be shut down while door is opened, it is beneficial to people health
*Ozone can release high concentration of ozone, effectively clear bacterial viruses *Hot air circulation system built-in central control protection, it will not burn the notes and documents etc.
*Ultraviolet wavelength of 253.7nm to irradiate bacteria and virus, and with protective cover to keep banknote safe
*Heat air with 65℃ temperature to penetrate notes for sterilization
*Self-control disinfection time from 0-60 minis by panel button
*Rapid sterilizing, only required 30 mins
*Gap-filling Glue to prevent ozone leakage

|
|
80L Banknote Sterilization Machine Images |